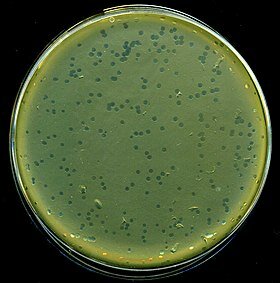
DESCUBRIMIENTO DEL VIRUS BACTERIOFAGO λ

-
 Ronald Ross
Ronald Ross
Trabajo sobre la malaria, mediante el cual ha mostrado cómo entra en el organismo y por lo tanto ha establecido los fundamentos para una exitosa investigación sobre esta enfermedad y métodos para combatirla. -
 Sir William Ramsay.
Sir William Ramsay.
Ramsay y su equipo, guiados por las consideraciones teóricas en las que se basaba la tabla periódica de Mendeléiev, buscó metódicamente los elementos que debían ocupar los huecos vacantes en el grupo de los gases inertes, lo que lo llevó a descubrir el neón, el criptón y el xenón al reducir el aire a bajas temperaturas a alta presión. -
 ALEKSANDR IVÁNOVICH OPARIN
ALEKSANDR IVÁNOVICH OPARIN
En la Tierra primitiva existieron determinadas condiciones de temperatura, así como radiaciones del Sol que afectaron las sustancias que existían entonces en los mares primitivos. Dichas sustancias se combinaron dé tal manera que dieron origen a los seres vivos. -
 Albert Szent-Györgyi
Albert Szent-Györgyi
Albert trabajó en varios centros científicos de Europa, obteniendo en 1927 un único gramo de esa misteriosa sustancia, extraída de la corteza suprarrenal de diferentes animales. Esa cantidad no era suficiente para poder describir la estructura de lo que más tarde denominó como "ácido hexurónico". Durante un viaje a Estados Unidos, consiguió extraer 35 gramos, gracias a que vivía cerca de una carnicería que le proporcionó suficiente corteza suprarrenal. -
 ARNE TISELUIS
ARNE TISELUIS
Es una técnica que emplean los científicos en el laboratorio utilizada para separar el ADN, el ARN, o moléculas o proteínas en base a su tamaño y carga eléctrica. Las condiciones utilizadas durante la electroforesis se pueden ajustar para separar moléculas en el rango de tamaño que se desee. -
 Harold Urey se preguntó si el átomo más pequeño, el hidrógeno, tenía diferentes isótopos, y calculó cómo deberían estar constituidos si ese fuera el caso. Al destilar hidrógeno líquido, se extrajo un isótopo de hidrógeno en 1932 que era dos veces más pesado que el hidrógeno normal. Se llamaba deuterio. El agua que contiene deuterio, demostró tener otras propiedades químicas que diferían del agua normal y, de varias maneras, el deuterio se volvió importante en la tecnología nuclear.
Harold Urey se preguntó si el átomo más pequeño, el hidrógeno, tenía diferentes isótopos, y calculó cómo deberían estar constituidos si ese fuera el caso. Al destilar hidrógeno líquido, se extrajo un isótopo de hidrógeno en 1932 que era dos veces más pesado que el hidrógeno normal. Se llamaba deuterio. El agua que contiene deuterio, demostró tener otras propiedades químicas que diferían del agua normal y, de varias maneras, el deuterio se volvió importante en la tecnología nuclear. -
 George Wells Beadle y Edward Lawrie Tatum
George Wells Beadle y Edward Lawrie Tatum
Tenían como objetivo originar individuos mutantes incapaces de sintetizar determinados compuestos. Estos organismos defectuosos solo sobrevivían si se añadía al medio el compuesto correspondiente. Mediante métodos adecuados demostraron que los individuos mutantes tenían afectado un gen, y que eso impedía la formación de una enzima, la cual permitía la formación del compuesto incapaz de sintetizar. -
ESTHER LEDERBERG
ESTHER LEDERBERG
La doctora fue la primera en descubrir que el fago λ puede invadir una bacteria e integrar su ADN en el cromosoma de la célula infectada, siguiendo un comportamiento hasta el momento desconocido. Después de la infección, el fago, en vez de multiplicarse rápidamente y destruir a su hospedador, incorpora su material genético al cromosoma bacteriano y logra pasar de una generación a otra sin causar inicialmente daño alguno. -
 SIR FRANK MACFARLANE BURNET
SIR FRANK MACFARLANE BURNET
Establece que el antígeno, al ingresar al organismo, selecciona a un clon linfocitario preexistente y específico para él induciendo su expansión. Las células pertenecientes a este clon comparten la especificidad, sin embargo presentan variedad funcional participando en las diferentes modalidades de las respuestas efectoras humorales y celulares. -
 James D. Watson, Francis Harry Compton Crick , Rosalind Franklin. Watson y Crick vieron unas fotos de una compañera de Wilkins, Rosalind Franklin. Rosalind tomo una fotografía usando los rayos x, la foto tenía forma de X y Watson y Crick pensaron que aquello tenía que ser una hélice doble. Probaron distintas posibilidades de organización del ADN hasta que todo encajó.
James D. Watson, Francis Harry Compton Crick , Rosalind Franklin. Watson y Crick vieron unas fotos de una compañera de Wilkins, Rosalind Franklin. Rosalind tomo una fotografía usando los rayos x, la foto tenía forma de X y Watson y Crick pensaron que aquello tenía que ser una hélice doble. Probaron distintas posibilidades de organización del ADN hasta que todo encajó. -
 Peyton Rous
Peyton Rous
Es un virus de clase VI con un genoma de ARN de sentido positivo que tiene un mediador de ADN. El RSV tiene cuatro genes:
gag - codifica las proteínas de la cápside
pol - codifica la transcriptasa inversa
env - codifica el gen de la envoltura
src - codifica una tirosina quinasa que une grupos fosfato al aminoácido tirosina en proteínas de la célula huésped.
RSV tiene repeticiones terminales que permiten su integración en el genoma del huésped y la sobreexpresión de genes RSV. -
 Bernard Katz
Bernard Katz
Utilizando las herramientas sencillas disponibles en los años cincuenta, midió las cargas eléctricas en el punto de unión entre los nervios y los músculos, cuando los primeros están transmitiendo. Para su sorpresa, también descubrió diminutas lecturas eléctricas cuando los nervios no estaban transmitiendo. -
 Los rayos X crean patrones de difracción que permiten a los científicos determinar sus estructuras. En la microscopía electrónica, haces de electrones crean imágenes de fenómenos microscópicos. Durante la década de 1960, Aaron Klug combinó métodos de cristalografía de rayos X con microscopía electrónica para estudiar estructuras complejas de ADN y proteínas en organismos como varios virus y en la cromatina, que forma los cromosomas dentro de los núcleos celulares.
Los rayos X crean patrones de difracción que permiten a los científicos determinar sus estructuras. En la microscopía electrónica, haces de electrones crean imágenes de fenómenos microscópicos. Durante la década de 1960, Aaron Klug combinó métodos de cristalografía de rayos X con microscopía electrónica para estudiar estructuras complejas de ADN y proteínas en organismos como varios virus y en la cromatina, que forma los cromosomas dentro de los núcleos celulares. -
 Georges Köhler, Cesar Milstein, Niels K. Jerne Los anticuerpos monoclonales son proteínas artificiales que actúan como anticuerpos humanos en el sistema inmunitario. Hay cuatro maneras diferentes en que se pueden producir y se nombran en función de lo que están compuestos: Murino, Quimérico, Humanizado, Humano
Georges Köhler, Cesar Milstein, Niels K. Jerne Los anticuerpos monoclonales son proteínas artificiales que actúan como anticuerpos humanos en el sistema inmunitario. Hay cuatro maneras diferentes en que se pueden producir y se nombran en función de lo que están compuestos: Murino, Quimérico, Humanizado, Humano -
 Susumu Tonegawa
Susumu Tonegawa
Descubrió que ciertos elementos de la masa genética (ADN) podían trasferirse y reagruparse en el transcurso del desarrollo al pasar de la célula embrionaria al estado del linfocito B. Demostró que cada linfocito es capaz de formar el anticuerpo necesario, es decir el anticuerpo que el organismo necesita en cada momento. -
 John Michael Bishop
John Michael Bishop
Gran parte de este trabajo se llevó a cabo junto con Harold Varmus en una asociación científica notablemente larga. Su logro más conocido fue la identificación de un gen celular (c-src) que dio lugar al oncogén v-src del virus del sarcoma de Rous, un virus cancerígeno que Peyton Rous aisló por primera vez de un sarcoma de pollo en 1910. -
 Alfred Gilman, Martin Rodbell
Alfred Gilman, Martin Rodbell
Son una familia de proteínas que pueden ser monoméricas o heterotriméricas. Estas son capaces de unirse a nucleótidos de guanina, de manera que son activas unidas a GTP hasta que lo hidrolizan a GDP, momento en el que pasan a estar inactivas. -
 Peter C. Doherty y Rolf M. Zinkernagel
Peter C. Doherty y Rolf M. Zinkernagel
Las investigaciones que se ven ahora recompensadas con el Nobel fueron realizadas entre 1973 y 1975. Su objetivo fue el estudio de la respuesta inmunitaria mediada por linfocitos contra las células infectadas por virus. El modelo fue un virus capaz de producir meningitis en ratones. Los ratones infectados desarrollaban ³células T asesinas² capaces de destruir, in vitro, células de ratón infectadas por el virus. -
 Roderick Mackinnon
Roderick Mackinnon
Uno de los procesos fundamentales de la vida es el transporte de moléculas de agua a través de la capa superficial de las células que componen los organismos. Los canales que permiten el paso del agua pero no de otras sustancias son cruciales para procesos como la capacidad del riñón para recuperar el agua de la orina. En 1990 Peter Agre logró aislar una proteína que demostró que era el canal de agua buscado. La proteína recibió el nombre de acuaporina. -
 Andrew Z.fire, Craig C. Mello
Andrew Z.fire, Craig C. Mello
Es un mecanismo de silenciamiento post-transcripcional de genes específicos, de modo que pequeñas moléculas de ARN complementarias a un ARNm conducen a la degradación de éste, impidiendo así su traducción en proteínas -
 Jack Szustak, Eliazbeth Blackburn, Carol Greider
Jack Szustak, Eliazbeth Blackburn, Carol Greider
Son estructuras situadas en el extremo de los cromosomas cuya misión es proporcionarles protección y estabilidad. A medida que las células se dividen, los telómeros se acortan y este acortamiento se contrarresta mediante la acción de la telomerasa. -
 Bruce Beutler, Jules Hoffmann
Bruce Beutler, Jules Hoffmann
Es un sistema de defensas con el cual usted nació y que lo protege contra todos los antígenos. La inmunidad innata consiste en barreras que impiden que los materiales dañinos ingresen en el cuerpo. Estas barreras forman la primera línea de defensa en la respuesta inmunitaria. -
 Tomas Lindahl, Paul Modrich, Aziz Sancar
Tomas Lindahl, Paul Modrich, Aziz Sancar
Algunas reacciones químicas que dañan el ADN pueden ser "deshechas" directamente por enzimas de la célula. Reparación por escisión: el daño a una o unas cuantas bases de ADN se suele arreglar al eliminar (escindir) y reemplazar la región dañada. -
 Jacques Dubochet, Richard Henderson
Jacques Dubochet, Richard Henderson
Entre 1975 y 1986, Joachim Frank desarrolló un método para analizar y fusionar imágenes bidimensionales borrosas del microscopio electrónico en una imagen tridimensional nítida. Las imágenes de microscopio electrónico proporcionan conocimiento que es importante para el desarrollo de productos farmacéuticos, entre otras cosas. -
 Sr. Stanley Whittingham, akira yoshino
Sr. Stanley Whittingham, akira yoshino
En 1980 John Goodenough desarrolló una batería de litio con un cátodo de óxido de cobalto que, a nivel molecular, tiene espacios que pueden albergar iones de litio. Este cátodo dio un voltaje más alto que las baterías anteriores. Las contribuciones de Goodenough fueron cruciales para el desarrollo de baterías de iones de litio, que se utilizan, por ejemplo, en teléfonos móviles y automóviles eléctricos. -
 David WC MacMillan, Benjamin List
David WC MacMillan, Benjamin List
Es un tipo de catálisis en la que se usa una molécula orgánica sencilla como catalizador, se ha convertido en un campo de trabajo de vital importancia dentro de la síntesis enantioselectiva y constituye uno de los avances más importantes en el área de la química del siglo XXI.
Looking for a timeline maker?
Create timelines for projects, roadmaps, history, lessons, legal cases, and stories with Timetoast. Timetoast is a timeline maker for work, school, research, and stories.
